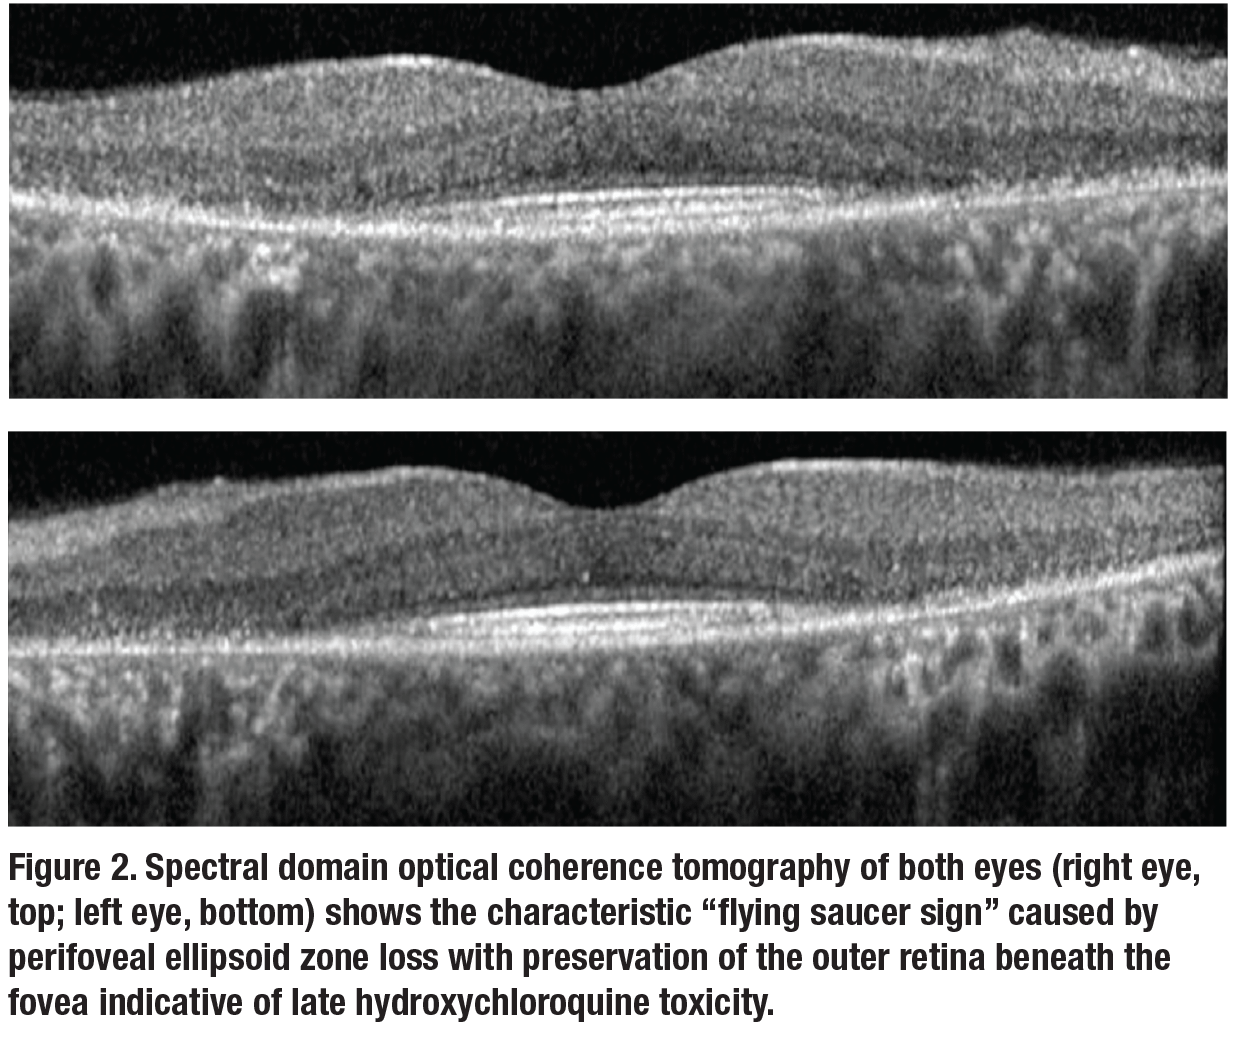

A 46-year-old Caucasian woman presented in 2015 for routine follow-up three years after her last examination. She had no other visual concerns.
 On re-examination, visual acuity was 20/20 and 20/30 in the right and left eyes, respectively. Anterior segment examination was unremarkable. Fundus appearance, spectral domain optical coherence tomography (SD-OCT), fundus auto-fluorescence (FAF) and automated visual fields are shown in Figures 1 to 3.Her medical history was notable for systemic lupus erythematosus (SLE) which was well controlled on hydroxychloroquine (HCQ) for the past 23 years. At her previous visit in 2012, before loss to follow-up, she was noted to have normal retinal morphology and function by multimodal imaging and functional testing.
On re-examination, visual acuity was 20/20 and 20/30 in the right and left eyes, respectively. Anterior segment examination was unremarkable. Fundus appearance, spectral domain optical coherence tomography (SD-OCT), fundus auto-fluorescence (FAF) and automated visual fields are shown in Figures 1 to 3.Her medical history was notable for systemic lupus erythematosus (SLE) which was well controlled on hydroxychloroquine (HCQ) for the past 23 years. At her previous visit in 2012, before loss to follow-up, she was noted to have normal retinal morphology and function by multimodal imaging and functional testing.
HCQ retinal toxicity
She was diagnosed with HCQ retinal toxicity, her rheumatologist was contacted and immediate HCQ cessation was recommended. She was switched to azathioprine, and the importance of regular ophthalmologic follow-up was emphasized.
The patient was lost to follow-up for three more years and presented again in 2018 with a chief concern of progressive blurred vision in both eyes. She noted that the azathioprine she was taking didn’t control her lupus as well as HCQ. Visual acuity was 20/30 in both eyes and multimodal imaging demonstrated progressive HCQ toxicity in both eyes (Figure 3C, page 12). Continued HCQ avoidance was recommended, a letter was sent to her rheumatologist and regular ophthalmologic follow-up was again emphasized.
 |
HCQ use to increase
HCQ was initially developed in the 1960s as an anti-malarial agent and is now used for a wide range of autoimmune disorders, including SLE, rheumatoid arthritis and mixed connective tissue disorders.1 The use of HCQ in SLE has been demonstrated to reduce the frequency of disease flares, renal disease, central nervous system involvement, thromboembolic events and mortality.2,3
Increasingly, the robust anti-inflammatory properties of HCQ are being investigated in dermatologic, cardiovascular, endocrine and oncologic diagnoses.2,4
Approximately 35,000 Americans were taking HCQ in 2016.5 Given its favorable therapeutic profile in a broad range of conditions, the long-term use of HCQ is expected to grow, particularly among SLE patients for whom many physicians now advocate early HCQ initiation. In this context, the burden often falls to the ophthalmologist to screen for vision-threatening HCQ retinopathy and recommend cessation of this life-altering and life-saving medication when such toxicity develops.1,5
The exact mechanism of HCQ retinal toxicity isn’t well understood, although multiple in vivo and in vitro studies have implicated drug accumulation in the retinal pigment epithelium and pigmented ocular tissues,
often at levels thousands of times higher than serum. This can lead to relentless retinal dysfunction that can continue even after cessation of HCQ therapy.1,4,6
Progression of retinopathy has been documented up to three years after discontinuation of the drug, further emphasizing the importance of early identification of toxicity, well before the characteristic ring of parafoveal RPE depigmentation (“bulls-eye”)
appears.7 It remains unclear why the
foveal region is particularly susceptible
to toxicity.1
 |
Duration increases risk
The risk of HCQ toxicity increases with duration of use, with 7.5 (by SD-OCT and 10-2 VF criteria) to 33 percent (by multifocal electroretinography [mfERG] criteria) of individuals developing toxicity at five years.5
Daily dosing level is the most critical determinant of risk as well as the only modifiable one. At 25 years, patients taking HCQ <4 mg/kg had a 10 percent risk of developing retinopathy compared to a 65 percent risk in those taking >5 mg/kg.4
Unfortunately, multiple studies support that a significant proportion of patients (13 to 75 percent) continue to receive toxic dosing, arising mostly from the use of outdated and unreliable ideal body weight calculations to ascertain safe daily dosing. For this reason, a number of medical societies now recommend 5 mg/kg of absolute body weight to calculate maximum safe dose of HCQ.4
|
 |
Managing HCQ toxicity risk
A smartphone application called Dosechecker, developed by Elliot M. Perlman, MD, and colleagues, has been reported to reduce the burden of manually calculating a low-risk HCQ dosing regimen for their patients.8 The application is available for both Apple and Android devices.
Other “major risk factors” include renal disease—as frequently found in rheumatologic conditions—and tamoxifen use (a fivefold increased risk of toxicity) for reasons that are yet unclear. Preexisting retinal and macular disease have also been cited as major risk factors, but no specific data supports this assertion.
Avoiding retinotoxic agents
Nevertheless, avoiding a retinotoxic agent in an already diseased retina seems reasonable, and preexisting retinal disease may interfere with the ability to detect early or subtle changes associated with HCQ toxicity. The absence of evidence also implies that isolated macular findings (eg, single drusen) may not be reason alone to withhold HCQ necessary to control systemic disease.
Age, hepatic disease and genetic factors (eg, ABCA4 or cytochrome P450 polymorphisms) are considered “lesser risk factors,” in that biologic plausibility exists but no definitive evidence that they contribute to toxicity.4 Table 1 (page 11) summarizes the risk factors set forth by the American Academy of Ophthalmology in 2016.
Bottom line
While HCQ toxicity can’t be reversed, it can be identified preclinically before symptomatic vision loss occurs.4 In the context of increasing use and persistently high-dosing regimens, universal screening HCQ-associated retinal toxicity is recommended for all HCQ users in the United States.5
The AAO released its revised guidelines for HCQ retinopathy screening in 2016.4 Prior surveys of ophthalmologists and rheumatologists have revealed incomplete understanding and implementation of AAO guidelines, which could result in HCQ toxicity or inappropriate cessation of a highly beneficial medication.1,6 We summarize the 2016 AAO guidelines (opposite page) for further review. RS
 |
REFERENCES
1. Yusuf IH, Sharma S, Luqmani R, Downes SM. Hydroxychloroquine retinopathy. Eye. 2017;31:828-845.
2. Alarcon GS, McGwin G, Bertoli AM, et al. Effect of hydroxychloroquine on the survival of patients with systemic lupus erythematosus: data from LUMINA, a multiethnic US cohort (LUMINA L). Ann Rheum Dis. 2007;66:1168-1172.
3. Fessler BJ, Alarcón GS, McGwin G, et al. Systemic lupus erythematosus in three ethnic groups: XVI. Association of hydroxychloroquine use with reduced risk of damage accrual. Arthritis Rheum. 2005;52:1473-1480.
4. Marmor MF, Kellner U, Lai TYY, Melles RB, Mieler WF. Recommendations on Screening for Chloroquine and Hydroxychloroquine Retinopathy (2016 Revision). Ophthalmology. 2016;123:1386-1394.
5. Browning DJ. The prevalence of hydroxychloroquine retinopathy and toxic dosing, and the role of the ophthalmologist in reducing both. Am J Ophthalmol. 2016;166:ix-xi.
6. Shulman S, Wollman J, Brikman S, Padova H, Elkayam O, Paran D. Implementation of recommendations for the screening of hydroxychloroquine retinopathy: Poor adherence of rheumatologists and ophthalmologists. Lupus. 2017;26:277-281.
7. Marmor MF, Hu J. Effect of disease stage on progression of hydroxychloroquine retinopathy. JAMA Ophthalmol. 2014;132:1105.
8. Perlman E, Friday R, Greenberg P, Browning D, Miller J. Dosechecker: Solving the hydroxychloroquine dosing dilemma with a smart phone app [abstract]. Arthritis Rheumatol. 2017; 69 (suppl 10) https://acrabstracts.org/abstract/dosechecker-solving-the-hydroxychloroquine-dosing-dilemma-with-a-smart-phone-app/. Accessed February 24, 2019.
9. Melles RB, Marmor MF. Pericentral retinopathy and racial differences in hydroxychloroquine toxicity. Ophthalmology. 2015;122:110-116.
10. Bulut M, Akıdan M, Gözkaya O, Erol MK, Cengiz A, Çay HF. Optical coherence tomography angiography for screening of hydroxychloroquine-induced retinal alterations. Graefe’s Arch Clin Exp Ophthalmol. 2018;256:2075-2081.



